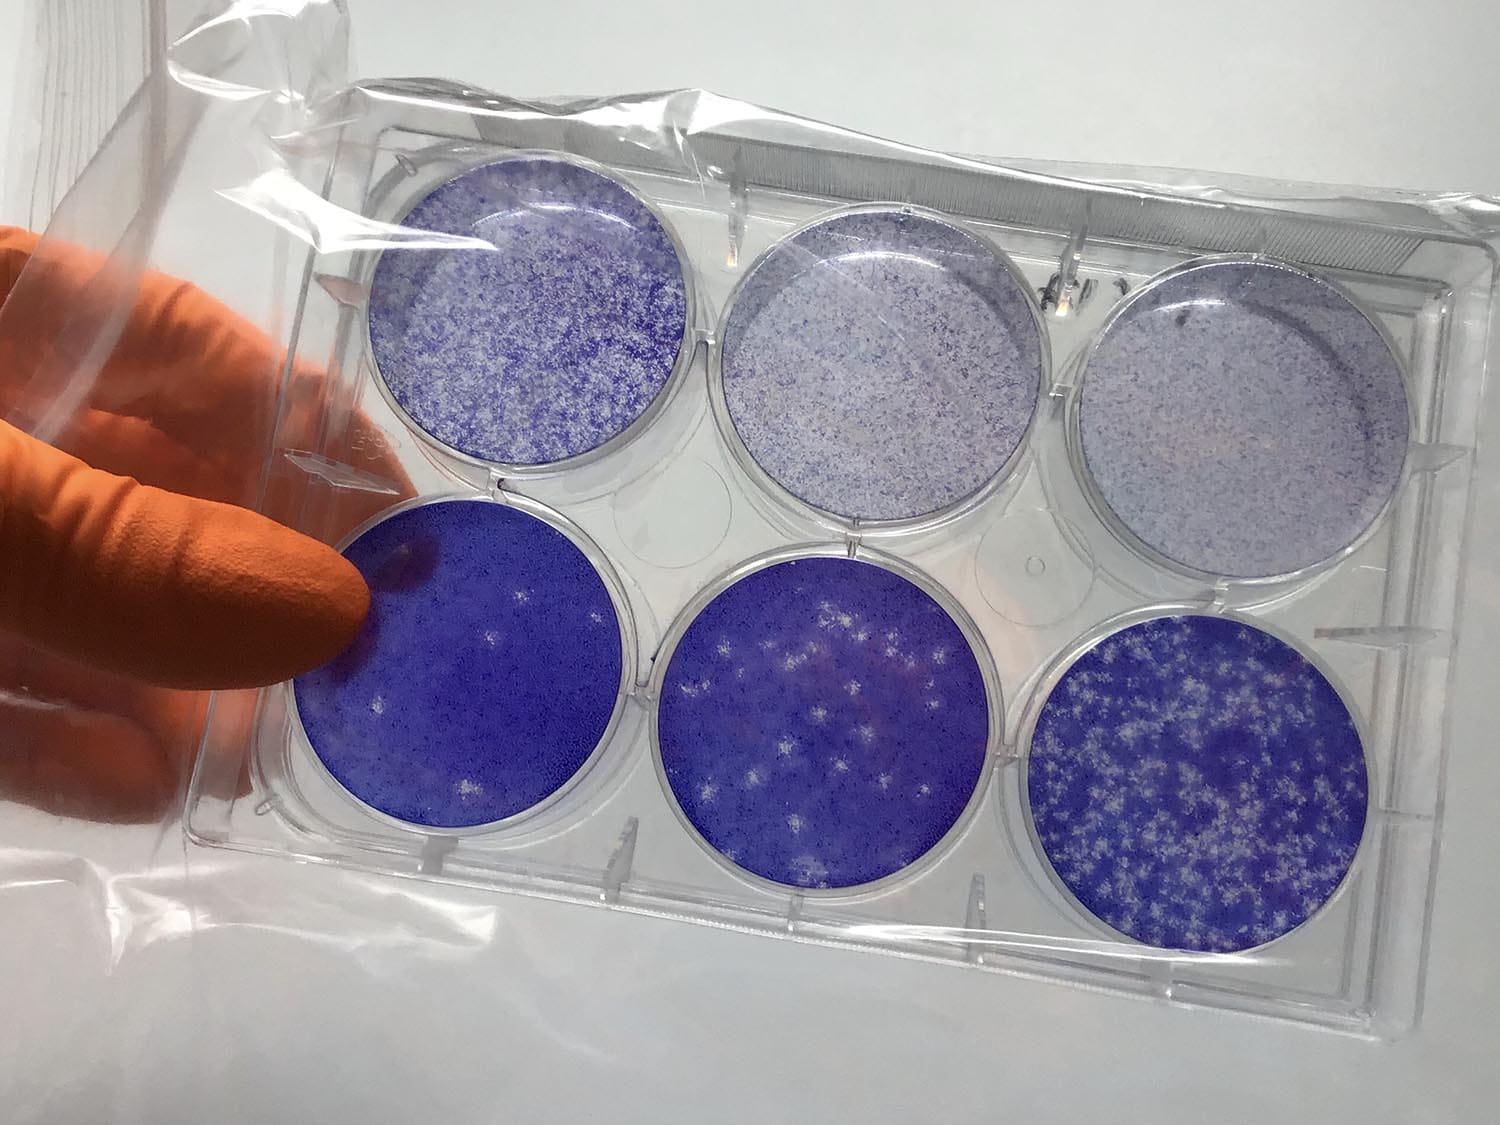
A plate in which a plaque assay has been performed to measure virus quantity in a sample. Cells are stained blue so that holes represent areas where viral infection has occurred

Development of a new assay that allows the functional activity of antibodies against nucleoprotein to be measured in blood samples
While infected with SARS-CoV-2, our immune systems generate antibodies against the Spike (S) protein on the virus surface, and against the Nucleoprotein (N) that packages the viral genome inside. Whilst S-antibodies have been well studied and neutralisation assays are widely available, the role of anti-N antibodies in immunity is not well understood. Further, standard tests that measure the activity of anti-S antibodies against the virus are unable to assess the virus-neutralising capacity of anti-N antibodies. Leo James’ group, in the LMB’s PNAC Division, has developed a new assay that can measure the anti-viral activity of anti-N antibodies in blood samples.
Standard assays for antibody neutralisation examine the ability of antibodies to directly block the entry of a virus into a cell. This means that these assays are only suitable for antibodies against viral surface proteins like Spike. Anti-N antibodies will not bind to the surface of the virus and stop it interacting with cells.
Although the neutralising capacity of anti-N antibodies couldn’t be measured with these assays, it was known that antibodies against nucleoproteins play an important role in controlling infection by many viruses, including HIV and influenza. Investigating the role of these antibodies, Leo’s group recently revealed a mechanism in which intracellular detection of anti-N antibodies activated a T cell response to help clear viral LCMV infection in mice.
Developing an assay to test for intracellular anti-viral activity of anti-N antibodies in SARS-CoV-2 infection of human cells meant that Anna Albecka-Moreau, a member of Leo’s group, had to set up a Containment Level 3 laboratory where it would be safe to work with live SARS-CoV-2 virus. Establishing this lab quickly after the start of the pandemic was possible thanks to a massive team effort, in particular Jillian Deans, the LMB’s Head of Health and Safety, Stephen Holmes, the Head of Estates, Chris Tate, Biological Safety Officer, and Emma Heath from the University of Cambridge Molecular Immunity Unit that is housed within the LMB.

The new assay, named EDNA (electroporated-antibody dependent neutralisation assay) exploits Trim‑Away, a technique developed by Leo’s group, in which antibodies are artificially inserted into cells through electroporation. In EDNA, the cells are then infected with SARS-CoV-2 and, one day later, the amount of viral replication that has taken place can be measured, either by looking at how many new virions are produced or quantifying the amount of viral RNA present. The virus is neutralised if electroporated anti-N antibodies activate the intracellular antibody receptor TRIM21, which then initiates degradation of the detected viral protein.
In collaboration with Helen Baxendale, a Consultant Clinical Immunologist at Papworth and Addenbrooke’s Hospitals, and David Favara, an NIHR Academic Clinical Fellow at Addenbrooke’s, Anna was able to use EDNA to screen serum extracted from blood samples from health-care workers and revealed a threshold titre of anti-N antibodies that could intracellularly neutralise SARS-CoV-2. In addition, Marina Vaysburd, another member of Leo’s group, was able to measure T cell activity against N in another extract from the same blood samples. With this, the team were able to demonstrate a correlation between a strong anti-N antibody response that could intracellularly neutralise the SARS-CoV-2 virus and the proliferation of N-specific T cells to further help the body’s defence.
This is the first assay that allows measurement of the functional activity of antibodies against nucleoprotein using blood samples. Although this assay is not suitable for population screening due to its requirement for CL3 lab space and use of live virus, it will enable further research into the correlations between antibody and T cell responses and between these immune responses and clinical outcomes. This could then identify new ways to better support the body’s defence against SARS-CoV-2, whether through development of vaccines that activate a response against N or direct modulation of the T cell response.
The work was funded by UKRI MRC and the Wellcome Trust.
Further references
A functional assay for serum detection of antibodies against SARS-CoV-2 nucleoprotein. Albecka, A., Clift, D., Vaysburd, M., Rhinesmith, T., Caddy, SL., Favara, DM., Baxendale, HE., James, LC. The EMBO Journal
Leo’s group page
Helen Baxendale’s page
Opening of LMB Containment Level 3 lab fast-tracked to help fight the COVID-19 pandemic
Previous Insight on Research articles
TRIM21 links antibody and T cell immunity to combat viral infection
Furin protease is not essential for SARS-CoV-2 infection
TRIM21 senses infection and triggers immune response inside cells


